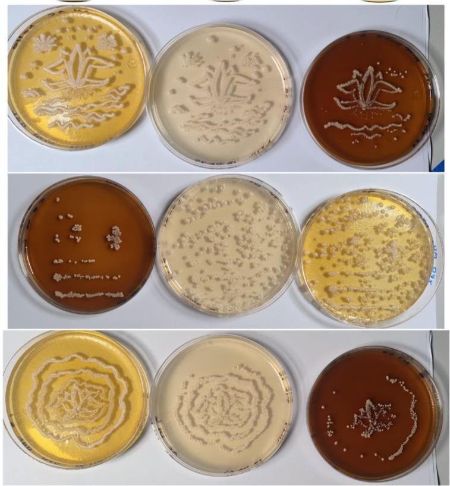

Fui yo
Este proyecto artístico-científico explora el papel crucial de los microorganismos, especialmente las levaduras, en las fermentaciones que dan origen al mezcal. Mediante un video en stop motion, se documenta el crecimiento de levaduras adaptadas al jugo de agave Agave salmiana, que revelan la frase “Fui yo” dentro de una caja Petri, cuestionando la visión antropocéntrica sobre la producción de destilados. Se utilizaron dos tipos de levaduras: una aislada de agave (adaptada) y otra de laboratorio (no adaptada), cultivadas en tripletes de medios diferentes: SC (blanco), YPD (amarillo) y jugo de agave (café). En total se realizaron cinco diseños trazados a mano en cajas Petri mediante técnicas microbiológicas, replicados y filmados en timelapse durante 4 días. El video final exhibe estas interacciones microbianas como una narrativa biocultural sobre la fermentación y el mezcal.
Técnica: Bucle de video, 1920 x 1080 px (relación 16:9)
Año: 2024
Sobre los artistas:
Alejandra Castro Flores
Artista visual, docente y gestora cultural nacida en la Ciudad de México en 1989. Es maestra en Estudios de Género por la UAQ y licenciada en Artes Visuales por la UNAM, donde también cursó un diplomado en gestión de proyectos artísticos. Su obra explora la corporalidad, el género y la relación entre cuerpo y entorno, influenciada por la gráfica y el arte feminista. Ha expuesto en espacios como el Museo de Arte de Querétaro, el CEART Qro y el Museo de San José (Uruguay). Ha sido reconocida con premios como La Cultura está en Nosotros (2023) y Apoyarte 2 (2020).

Lucía Guadalupe Morales Reyes
Investigadora y docente nacida en la Ciudad de México en 1984 y adscrita al Laboratorio Internacional de Investigación sobre el Genoma Humano (LIIGH) de la UNAM, en Querétaro. Su trabajó se centra en la evolución, diversidad y adaptación de levaduras e híbridos. A través de la biología evolutiva y la genómica comparativa, estudia cómo los microbios interactúan y se adaptan a prácticas tradicionales vinculadas a la fermentación. Lucía combina excelencia académica con una vocación por construir espacios científicos inclusivos y respetuosos. Impulsa una ciencia rigurosa, abierta y comprometida con la equidad, y promueve la participación de mujeres y jóvenes del sur global en la investigación de frontera, convencida de que el conocimiento debe ser compartido, nutrido por la diversidad y orientado al cambio social. Mediante su investigación, publicada en revistas científicas internacionales, ha contribuido a comprender la historia evolutiva, la diversidad biológica y los genomas del mundo microscópico.

